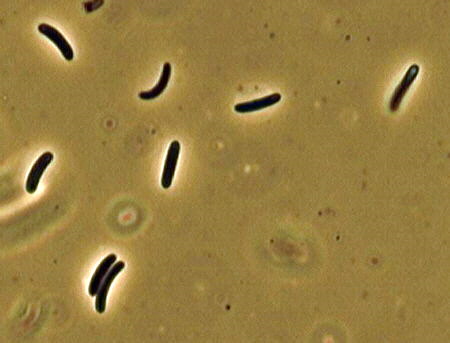

The Fifth Kingdom - Chapter 4b
A Survey of Ascomycetous Holomorphs
New Phylogenetic System - only some groups of which * are covered in this chapter.
Phylum 6 Ascomycota -- with three Subphyla
Subphylum Taphrinomycotina
Class Taphrinomycetes
Order Taphrinales*
Class Schizosaccharomycetes*
Class Pneumocystidiomycetes
Class Neolectomycetes
Subphylum Saccharomycotina
Class Saccharomycetes
Order Saccharomycetales* - see Chapter 6
Subphylum Pezizomycotina
Class Pezizomycetes (operculate discomycetes)
Order Pezizales*
Class Dothideomycetes
Order Dothideales*
Order Capnodiales*
Order Myriangiales
Order Pleosporales*
Order Botryosphaeriales
Order Hysteriales
Order Patellariales
Class Eurotiomycetes
Order Eurotiales*
Order Onygenales*
Order Coryneliales
Order Mycocaliciales
Order Chaetothyriales
Order Pyrenulales
Order Verrucariales
Class Laboulbeniomycetes
Order Laboulbeniales*
Order Pyxidiophorales
Class Lecanoromycetes
many orders of Lichens - see Chapter 7
Class Arthoniomycetes
Order Arthoniales
Class Leotiomycetes
Order Helotiales*
Order Erysiphales*
Order Rhytismatales*
Order Cyttariales*
Order Thelebolales
Class Sordariomycetes
Order Sordariales*
Order Ophiostomatales*
Order Diaporthales*
Order Coniochaetales
Order Chaetosphaeriales
Order Hypocreales* (includes Clavicipitales*)
Order Microascales
Order Melanosporales
Order Coronophorales
Order Xylariales*
Order Trichosphaeriales
Order Phyllachorales
Order Meliolales*
Order Lulworthiales
Order Calosphaeriales
Hotlinks to Traditional Orders: Taphrinales - Pezizales - Elaphomycetales - Sphaeriales - Sordariales - Diatrypales - Hypocreales - Diaporthales - Leotiales - Cyttariales - Rhytismatales - Clavicipitales - Erysiphales - Onygenales - Eurotiales - Ophiostomatales - Meliolales - Laboulbeniales - Dothideales
Now to put anamorph and teleomorph together, and talk about the whole fungus (the holomorph). If you have any queries about anamorph-teleomorph connections in ascomycetes, there is now a web site at which you can look them up. Click here
Enter Peziza and see how many different connections you retrieve. Try Acremonium (a hyphomycete with single, generalized phialides) and see how many holomorphs come up. Why do you think there are so many? I will briefly survey the more important orders of ascomycetes, linking the different life-forms together in as many cases as possible. Although 50 orders of ascomycetes (quite a few of them almost entirely lichenized) were recognized in one recent classification, you may be relieved to discover that I will show examples of only 19, and provide a key to only 17 (mainly non-lichenized orders - see Chapter 7 for some of the others)
(1) Order Taphrinales Subphylum Taphrinomycotina: 9 genera, 120 species. This is an outlying group which causes serious diseases of some plants in the Rosaceae (e.g., Taphrina deformans causing peach leaf curl) and the Amentiferae (e.g., Taphrina populina on poplar).
Here is Taphrina deformans attacking peach leaves in New Zealand. But the same picture could also have been taken in North America or Europe. The leaves become thickened, distorted and often yellow or reddish in colour. This fungus has four unique or unusual features.

(A) The assimilative mycelium is dikaryotic -- this would immediately distinguish it from most other ascomycetes (and indeed raises questions about the taxonomic position of this order).
(B) It produces an exposed layer of asci on the surface of the host leaf (below). Since there is no surrounding or supporting fungal tissue, there is nothing we could call an ascoma.

(C) The ascospores often bud in a rather yeast-like manner, even while still inside the ascus (below and references "Ac" and "As").
(D) When the asci open to release their spores, they tend to split across the tip, rather than around it (bottom, left references "As" and "A"), so they are not like the rest of the operculate group -- compare them with the asci of the Pezizales, the next order. As you may have guessed by now, this group sits uneasily among the other ascomycetes, and one eminent authority grouped the Taphrinales with the smut fungi (see order Ustilaginales in Chapter 5f); both are yeast-like when grown in axenic culture.
The anamorph of Taphrina, the phase in which it grows in culture, is a single- celled budding yeast named Lalaria.
Compare its features for yourself with some of the orders that follow.

Taphrina populina (below) attacks leaves of poplar.
WEB IMAGES

Taphrina amentorum (below right) attacks the green fruits of Alnus (alder), turning them bright red. This illustration is from a wonderful book, Fungi of Switzerland - Volume 1 - Ascomycetes by Breitenbach and Kraenzlin. I recommend this book to all mycologists. The series is undoubtedly the best of its kind, with excellent illustrations of macroscopic and microscopic features, as you see here, plus detailed descriptions on the facing pages. Check it out...
Pneumocystis carinii, Class Pneumocystidiomycetes, the causal agent of a lung disease that affects many AIDS sufferers, fits into the Subphylum Taphrinomycotina.
Series Unitunicatae-Operculatae
Order Pezizales Class Pezizomycetes Subphylum Pezizomycotina: 150 genera, 900 species. The 'operculate discomycetes' -- we'll look at 7 of the 15 families currently recognized.
(a) Family Pezizaceae. Classic 'cup-fungi' producing apothecial ascomata that are usually shaped more like saucers or goblets, usually without stalks, and found growing on wood, dung or soil. They vary so much in colour, texture and ornamentation that most discomycete specialists split the Pezizaceae into several tribes or even families. Their asci have a diagnostic pop-open lid or operculum, and the tips of the asci are amyloid (sometimes expressed as I+ -- this means giving a blue, starch-like reaction in an iodine solution known as Melzer's reagent).
A small species of Peziza (below, as seen through the dissecting microscope) often crops up on soil in greenhouses, frequently preceded by its blastic-synchronous Chromelosporium anamorph (the whitish fuzz at lower left).

Microscopic detail of both reproductive phases is given in the diagrams (below).

The Chromelosporium anamorph of Peziza is shown here under phase-contrast illumination.

Larger species of Peziza, producing thin, rather brittle apothecial ascomata several centimetres across, with light brown or orange hymenia, can be found on the ground in Spring and Fall (below).

(b) Family Sarcosomataceae.
This family contains wood-inhabiting fungi with apothecia that are often stalked (stipitate), relatively tough, and brightly coloured. The asci are sub-operculate, and non-amyloid. The scarlet cups of Sarcoscypha coccinea (below), growing from buried hemlock branches, brighten up the early Spring in Canadian woodlands.

The brightly coloured, stalked apothecia of Cookeina (below) are a common sight in the Neotropics, and may provide a camouflaged perch for the tiny but equally colourful poison arrow frog, as this National Geographic cover shows.

Urnula (below) is another striking example of the Sarcosomataceae.

(c) Family Pyronemataceae.
Aleuria aurantia, the orange peel fungus (below),
is common along the edge of logging roads on Vancouver Island.


The picture above is from Fungi of Switzerland Volume 1 by Breitenbach and Kraenzlin. Note how the field picture is flanked by details of the diagnostic microscopic features. This book is the best of its kind, and belongs on every mycologist's shelf.
Another example of the Pyronemataceae from this magnificent book is Humaria hemisphaerica (above),
Scutellinia scutellata (below), [Pyronemataceae] its orange apothecia rimmed with dark hairs (which give it the common name 'eye-lash fungus', and with non-amyloid asci, is one of the commonest cup-fungi, growing on rotten wood. Anamorphs don't seem to be produced by many members of this family.

Caloscypha fulgens is a common spring discomycete in western North America. It is easily recognized by its brilliant orange apothecia which soon become externally tinged blue or greenish-blue. These specimens grew in May along a trail in John Dean Park near my home.

The phase contrast photomicrograph
below shows asci and ascospores of
Caloscypha fulgens.
There are 8 globose, uniseriate ascospores.
Some genera, such as Genea
(below), produce closed but hollow ascomata. The asci are cylindrical or clavate,
and are arranged in an extensive flat hymenium lining the ascoma, but they do not shoot their spores. These apparently
contradictory features show that members of this family are becoming sequestrate
(their fruit bodies do not liberate spores at maturity) and hypogeous (they produce their ascomata underground).

Geopora cooperi, here seen bisected,
is also sequestrate and hypogeous, but now the air space inside the
fruit body is much less than in Genea: another step on the way to
becoming a truffle (see below, and Family Tuberaceae).

This evolutionary process is diagrammatically illustrated here.
The fourth and final step sees the elimination of air spaces altogether, and
is a solid truffle of the genus Tuber, Family Tuberaceae -- see
family (g)
below.
Evolution toward the sequestrate and hypogeous
condition is not restricted to the Pyronemataceae, but can also be seen operating in several
other families of the operculate discomycetes.

(d) Family
Ascobolaceae.
Students who have
followed the succession of fungal fructifications appearing on horse dung will be
familiar with the two most important genera of this largely coprophilous
(dung-inhabiting) family -- Ascobolus
and Saccobolus. Both produce minute, translucent apothecia (seen under the low
power of the dissecting microscope, below; higher power, 2 images down).

The dark dots are
mature asci, which are broad, and project from the hymenium when mature, so that
their tips may become oriented toward the
light.


The 8 ascospores have a purple or brown outer wall layer. Ascobolus (above),
like most other ascomycetes, shoots ascospores individually. Saccobolus
(below) atypically sticks all eight together in a bundle, and they are expelled as a
single projectile, which gives them extra range. I haven't seen any anamorphs in this
family, though a few are known.

(e) Family Helvellaceae.
These mostly
spring-fruiting fungi have large and unusually configured apothecial ascomata. All are
stalked, with beige to brown, hymenium- covered caps. Helvella species (H.
elastica, below, left; H. crispa, below, right) have a drooping flap on either side,
and are called saddle fungi. Abbott and Currah
(1997) gave a good revision of this family.


This is Helvella lacunosa...

...and this is a cross section of its stipe -
surely one of the most interesting of any fungus. Its structure
gives it a lot of the stiffness of a girder, for a minimal investment in
materials.

The ascomata of Gyromitra species (bottom right), are among the largest
ascomycete fructifications, and some species contain the toxin gyromitrin, a precursor of the deadly
monomethylhydrazine.
By causing some fatal poisonings, the Spring-fruiting Gyromitra
esculenta (bottom left) has earned its place in Chapter 22 on poisonous
mushrooms.


It is vital for morel-hunters to be able to distinguish the convoluted head of
Gyromitra,
the false morel, from the ridged and pitted head of the delicious true morel
(see below)


...and here's a
March 2000 collection we made of Gyromitra infula on a
rotten log (note that superficially, it looks more like a Helvella, but
is distinguished by its spores, which have an apiculus at each end.
Occasionally you may find a specimen that looks as if a mould is
growing on it. Sometimes there really is a mould attacking it, but
it's also likely that what you're seeing is a deposit of the fungus's
own ascospores, as is the case with the Gyromitra esculenta below,
which was sitting in very still air (the asci are
shown in the second picture, and the beautifully ellipsoidal spores,
each containing polar oil droplets, in the third photo,
taken under phase contrast optics).



In 1973 Luttrell provided the following
generalizations about ascospores.
(1) If they were unicellular, the odds were 9:1 that they belonged to a
Euascomycete (one not producing bitunicate asci).
(2) If they had a germ slit, a germ pore, or were globose, the odds were < 9:1 that they were produced by a Euascomycete.
(3) If they were allantoid (sausage-shaped), the odds were 100% that they
were produced by a Euascomycete.
(4) If they were didymospores (2-celled), the odds were 2:1 that they were
produced by a bitunicate ascomycete.
(5) If they were phragmospores or dictyospores, the odds were 9:1 that they
were produced by a bitunicate ascomycete.
Check these concepts out as you work through the groups...
(f) Family Morchellaceae.
While Gyromitra
is one of the few lethally toxic fungi, its cousin, Morchella, the true morel
(below, left) is one of the finest of all edible fungi. The
left-hand picture
below is of my first morel of the year 2000 (Morchella angusticeps,
found near Lake Wenatchee, Washington State). Species of Morchella have
a broad, hollow stalk, and a pitted and ridged, sponge-like, more or less conical or
ellipsoidal head. Since the hymenium doesn't cover the ridges (as you can see in the
transverse section, below centre), it seems likely that a morel is a compound ascoma, each
pit representing an individual apothecium. The anamorph of the morel is a
blastic-sympodial hyphomycete, Costantinella, which I have often found
in the Fall growing on
soil beside trails in Algonquin Park, Ontario
(below, right).



Morels have a broad geographic range, but are common in relatively few
areas, of which Michigan is perhaps the best-known. People throng to the woods in May to
hunt this elusive delicacy, and Boyne City holds an annual morel-hunting
championship. When Dutch elm disease was killing millions of elm trees, morels
sometimes fruited profusely around recently dead trees. In recent years they have
also been collected in large numbers on burned over areas of western forests. Morels are discussed as a a delicacy in Chapter 18.
Just to confuse the issue, a second genus of Morchellaceae, Verpa, also fruits in May. Species of Verpa aren't
toxic, but neither are they good to eat. Verpa bohemica
(below), found at Lake Wenatchee, like the morel above, is called the
wrinkled thimble-cap.


Verpa
bohemica (above, and far left), looks like a morel, but it is easy to tell the difference by
bisecting the fruit bodies vertically. While the cap and stalk of the true morels (the two right-hand
specimens in each picture) are firmly united, the cap of Morchella semilibera (first
from left, next to the Verpa) is, as its name implies, half-free, and that of Verpa
is attached only at the apex, as you can see in the sectioned fruit bodies in the lower photograph. In addition, the stipe of Verpa
(far left) is
'stuffed' with cottony mycelium, while
those of the Morchella species are completely hollow.

The family below is a group of
Pezizales that has evolved into an underground fruiting
habit - they have become sequestrate. This footnote is just to let you know
that there are also several genera in the Morchellaceae
that have become sequestrate (truffle-like). These are
Kalapuya, Fischerula, Imaia and Leucangium.
Some recent illustrations of Kalapuya are shown below
(Trappe et al. 2010).

(g) Family Tuberaceae
Order Pezizales
Class Pezizomycetes...
...the truffles. Here, the
evolutionary process still active in the Geneaceae, Otideaceae, etc. has run its course.
The ascomata are sequestrate, hypogeous and solid (no air spaces any more --
as you can see in this bisected
specimen of Tuber aestivum, which a truffle dog brought to me at
Scheggino in Italy)

The asci, produced in a highly convoluted hymenium, are rounded and thin-walled (those of Tuber
albidum are shown below) with no trace of an operculum or other shooting mechanism,
and usually contain only 1-3 spores.

The ascospores of truffles have complex, highly ornamented
walls. They come in two basic patterns - spiny (bottom left) and lacunose
(bottom right). These SEM pictures show single ascospores of (bottom left) the black truffle, Tuber
melanosporum (the French favourite) and (bottom right) the white truffle, Tuber magnatum
(which the Italians prefer). You might be interested in my own
ratings, given in Chapter 18).


Only by examining a series of microscopic characters, and
considering some intermediate forms that trace the probable course of evolution in the
group (a set of diagrams given earlier) can we tell that these fungi are related to the
'operculate discomycetes.'
Although it doesn't make taxonomy any easier, we must now logically place these hypogeous
(underground) families with their epigeous (above-ground) forebears in the order
Pezizales. The hypogeous habit has
necessitated the evolution of new methods for passive spore dispersal, in which some
agency other than the fungus supplies the energy for dispersal. Members of the
Tuberaceae,
especially species of the genus Tuber (the true truffles), have achieved this by
developing what can only be called fascinating smells. These odours are released when the
ascospores are mature, and lead many mammals unerringly to the ascomata, which they
unearth and consume, subsequently depositing the still-viable spores elsewhere. Tuber
is dependent, not only on mammalian vectors, but on the roots of oak and hazelnut trees,
with which it establishes a symbiotic ectomycorrhizal relationship (see
Chapter 17). Tuber melanosporum and Tuber magnatum are, respectively, the black
and white truffles of French and Italian haute cuisine, perhaps the most highly esteemed
(and certainly the most expensive) of all edible fungi, and so are discussed in
detail in Chapter 18.
Molecular studies
(Urban et al., 2004) have shown that certain species of Tuber have
previously unknown hyphomycetous anamorphs resembling
Geniculodendron, with
branched conidiophores and blastic-sympodial conidiogenesis.

(3) Order Elaphomycetales:
1 family, 2 genera, 21 species. At first sight the hypogeous ascomata of Elaphomyces
(below) look just like truffles; and they're even called 'deer truffles'...

...but they have no hymenium - the basically spherical, non-shooting asci
(two stained asci are shown here) are produced
randomly throughout the interior of the ascoma. Elaphomyces no longer offers much
in the way of visual clues about its possible epigeous ancestors, so only molecular
techniques can help us decide its relationships. These
techniques are what placed a strange new fungus from the forests of Guyana
right next to Elaphomyces...

The two pictures below [from Miller et al. (2001)
Mycol. Res. 105: 1268-1272] show a fungus that clearly has a volva and a
stipe (stalk). It was discovered only in 1998 and described in
2001. It doesn't look like Elaphomyces (see picture above),
and was almost described as a basidiomycete, a member of the
Tulostomataceae (the stalked puffballs). But repeated molecular
results from different collections showed that it is in fact an
ascomycete very closely related to Elaphomyces, and has
apparently evolved major new characters as a way of dealing with a very
wet environment -- it needed to get its spores not only out of
the soil, but above it. We welcome Pseudotulostoma
to the known fungi.

Series
Unitunicatae-Inoperculatae

(4) Order Sphaeriales Class Sordariomycetes: 225 genera, 1300 species. Many members of this group produce dark, brittle, globose to pear-shaped individual perithecial ascomata with prominent ostioles. Others have many perithecial cavities immersed in a single stroma to form a compound fructification, as in Xylaria below The asci often have an apical ring or sphincter, which is usually, though not always, amyloid (stains blue in iodine). Thread-like, sterile elements called paraphyses are present between the asci in the hymenium of some members, absent from others. Ascospores can be light or dark, simple or septate, with or without germ pore or slit, sometimes with gelatinous sheaths or appendages.
The compound fructification of Xylaria, a
common wood-inhabiting genus, has hundreds of perithecial ascomata just below the surface,
as a you can see in the transversely cut specimen (below, left). Each
perithecium contains many asci, as you can see in the section (below, centre).



The asci are inoperculate, with an amyloid apical ring (stained
blue - above, right)
and contain 8 darkly pigmented, asymmetrical spores, which will eventually be shot out through the ostiole.
Xylaria hypoxylon is another common and easily recognized
species. The upper part of the compound ascoma is covered with the whitish conidia
of the blastic-sympodial anamorph (which, strange to say, has not been named).
This species is often seen on fallen, rotting
branches.

This order also includes such pathogens as
Entoleuca mammata
(formerly Hypoxylon pruinatum) (below),
which causes poplar canker, a disease that kills millions of trees every year. The
extensive, more or less elliptical cankers (below, left) develop groups of perithecial ascomata
(light circular patches, below, right) after the tree cambium has been killed.


For more information about the Xylariaceae, please consult the web
site built by Jack Rogers, an authority on this group, at this website
This deals with all the main genera, and has many useful
illustrations and keys.
Swiss research has found a new way of re-creating the
sound quality of a Stradivarius violin in modern replicas - inoculate the
wood from which the violin is made with Xylaria longipes. The
fungus metabolizes some of the substrate as it grows, thus reducing the
density of the wood and apparently improving the tonal qualities of the
violin.
The genus Annulohypoxylon has recently (2005)
been erected for species of Hypoxylon distinguished by molecular
characteristics and by the presence of: (1) a discrete carbonaceous layer
enclosing each perithecium, and (2) ostiolar discs.
(5) Order Sordariales
Class Sordariomycetes:
5 families, 75 genera, 600 species. This is a generally saprobic group producing solitary
perithecial ascomata, and found on dung or decaying plant remains. Their asci sometimes
have non-amyloid apical sphincters, and sometimes lack any apical apparatus. Several
members of this order are important tools in fungal genetics and biochemistry.
First and
foremost is Neurospora, which has justifiably been called the 'Drosophila
of the fungus world'. It was on Neurospora crassa that the science of haploid
genetics was founded. The uses of Neurospora and Sordaria mutants are
explored in Chapter 10.
Neurospora has Chrysonilia anamorphs (below) that
closely resemble the Monilia anamorphs of Monilinia (Sclerotiniaceae,
Leotiales).
When I was in China some years back, I noticed the vivid yellow-orange
fruiting of Chrysonilia on the husks of corn cobs thrown
away near the great wall at Badaleng.
This slide prep. shows the branched blastic-acropetal chains of conidia
formed by this fungus (stained blue).
Many species of Sordaria and Podospora fruit on
herbivore dung, and shoot their ascospores from perithecial ascomata whose necks, like
that of the Sordaria on the bottom left, are phototropic (point toward the
light). Look for the apical ring mechanism in the Sordaria asci (bottom right),
seen under phase contrast illumination.


Different species of Podospora have 4, 8 (as on the left), 16,
32, 64, 128, 256, 512, 1024 or 2048 ascospores per ascus.
How many do you think there are
in each of the two asci of Podospora tarvisina on the right?


The various combinations of tubular and gelatinous ascospore appendages in
Podospora not only help in species identification, but also stick the spores to
grass after they have been shot away from the dung on which the ascomata develop. Some
species of Podospora have Phialophora anamorphs.


Podospora has been analyzed from the
molecular point of view and found to be a polyphyletic genus. Species
bearing plates of agglutinated hyphae (see middle left-hand photo above)
were found to be monophyletic, and have been moved to Schizothecium.
Chaetomium (below) is an important cellulolytic genus that damages
fabrics and paper, especially in the tropics. It differs from most other Sordariales in
that its asci, though cylindrical, deliquesce or autolyse at maturity. Since they
don't shoot their spores, they have no apical ring mechanism.

The mucilaginous,
lemon-shaped ascospores (below - two species are present
here) ooze out of the ascoma into a characteristic mass of coiled (above)
or dichotomously branched hairs that develop on the top of the ascoma. Dispersal must be
by rain or arthropods. Chaetomium has Botryotrichum anamorphs

(6) Order
Diatrypales
Class Sordariomycetes:
20 genera, 125 species. The bark on dead branches of
trees often develops eruptions that mark the extensive immersed stromata (compound
ascomata) and the grouped ostioles of such common genera as Diatrype
and Quaternaria.
The first picture is of the restricted circular stromata of Diatrype disciformis and is taken from
Jahn's fine book about fungi that grow on wood ('Pilze die an Holz wachsen').

The next picture shows the perithecial
cavities that are revealed by slicing an extensive Diatrypalean stroma
with a sharp blade.

The following four pictures are derived from a
Diatrype I found covering dead branches of a Horse chestnut tree (Aesculus)
in my garden in February of 2008.

The stroma covers most of the branch under the
thin bark, which is peeling away, and the protruding ostioles of the
individual perithecial cavities are clearly visible.

This is a
phase-contrast
photomicrograph of a single ascus from a squash of the gelatinous contents
of one of the perithecia.
You can see a dark apical body, and count 8 curved
ascospores.

These are free ascospores (again
seen by
phase-contrast).
Note that they are curved.
We describe them as sausage-shaped or allantoid.
Another informative pair of illustrations, of Diatrype disciformis (below),
come from the highly recommended Fungi of Switzerland. The
reference is at the end of the chapter.
(7) Order Hypocreales
Class Sordariomycetes:
80 genera, 550 species.
This order is recognized by its brightly coloured, simple or
compound, perithecial ascomata -- usually yellow, orange or red -- which are fleshy or
waxy in texture, and usually borne on supporting layers of mycelium (subicula) or in
stromata. Four genera are especially well-known.
1) Nectria
(27 species) has bright red, superficial
perithecia (bottom left) containing 2-celled (didymosporous) ascospores. Some species cause
cankers and die-backs of trees.
Nectria sensu lato has a variety of conidial
anamorphs, all of them phialidic. The erumpent sporodochia of one commonly encountered
phialidic anamorph, Tubercularia, cause a condition known as coral spot (bottom right).


The picture below shows the
yellow-orange Tubercularia anamorph growing beside the
dark red Nectria perithecial ascomata. It is interesting and a little
unusual to see both phenotypic expressions of the genome being produced simultaneously.

However, the most economically important of the nectriaceous anamorphs
are certain Fusarium species (below, right), many of which cause destructive wilt
diseases of higher plants, or produce mycotoxins.
(2) Gibberella
also has Fusarium anamorphs, which are producing the reddish pigment seen in
the picture (bottom left)
Fusarium (bottom right) produces curved phragmoconidia, frequently
with an angled 'foot cell,' from clusters of phialides.


The
picture below shows Gibberella (the
dark bodies are its perithecia) and its Fusarium
anamorph (reddish-orange) growing together on a corn cob.

One species of Gibberella causes a disease of rice called
'foolish seedling' in which seedlings grow
too rapidly and consequently fall over. The active principle, a plant growth hormone
called gibberellic acid, has been extracted and is now widely used to stimulate plant
growth.
(3) Hypomyces.
In this series of five pictures, we zoom in on
Hypomyces
lactifluorum, an orange fungus which, like other species of the
genus, parasitizes basidiiomycetes, in this case the agaric genera Lactarius
and Russula...

...producing a layer of tissue that completely covers the
gills and suppresses their development...

...then developing thousands of bright orange-red perithecial ascomata
all over the surface of the subiculum.
The Hypomyces completely envelops the aborted mushroom and its colour gives the host-parasite combination the name 'lobster fungus'. Strangely enough, this monstrosity is edible, though I regret to have to tell you that it does not taste like the divine crustacean.

Here is the ostiolar region of one Hypomyces perithecial ascoma.
Note the pseudoparenchymatous wall of the perithecium, and some of the narrow asci which have been squeezed out during the preparation of the slide...

...and here are some of the characteristic spindle-shaped, 2-celled, colourless ascospores. You can see the median septum and the rough walls.
Twenty-one species of Hypomyces that grow on fruit bodies of
various basidiomycetes produce anamorphs belonging to the hyphomycete genus, Cladobotryum, which has an unusual
blastic-retrogressive method of forming conidia
(see Chapter 4a).

If you need to identify a species of Hypomyces, there is now a fine
new fully illustrated resource on the web here
(4) Hypocrea forms fleshy stromata on wood (below). The dark spots
are the ostioles of the embedded perithecial cavities.
The asci are typically 16-spored, the ascospores uniseriate, as you can see in the second picture
The teleomorph of Hypocrea is recorded far less often than its green-spored, phialidic anamorph, Trichoderma (lower right) which, because some species are broad-spectrum mycoparasites, and others produce cellulases and antibiotics, is one of the most important genera of moulds in forest soils. It is now being exploited in biological control of pathogenic fungi (see Chapter 14), and in the production of enzymes which can convert cellulose to glucose.
Chaverri and Samuels (2003) give a detailed
treatment of Hypocrea species with Trichoderma anamorphs.



The diagrams below show the wide range of anamorphs found in the Nectria-like members of the Hypocreales. They all have phialides as their conidiogenous cells, though the different ways in which these are arranged, and the varying shape and septation of the conidia, place them in many different anamorph-genera (named in the drawing).

(8) Order Diaporthales, Class Sordariomycetes: 90 genera, 500 species. Here several beaked, perithecioid ascomata are usually immersed in a single stroma (as in Diaporthe impulsa, below).
Paraphyses are often absent; and the asci become free inside the ascoma, and then autolyse. This rather paradoxical situation suggests that evolution is in active progress here. Two important genera stand out. Cryphonectria (Endothia) parasitica causes chestnut blight, which has almost extinguished an important species of North American tree in about 50 years: you can read the full story in Chapter 12. Incidentally, the fungus is still found attacking chestnut shoots which continue to arise from the roots of trees 'killed' earlier. Another member of this order, Gaeumannomyces graminis, which causes 'whiteheads' or, take-all' of wheat, is common. It rots the roots of afflicted plants, and causes premature drying out of the plant, sometimes reducing yields to zero. Anamorphs are coelomycetous.

Leucostoma niveum (above), as illustrated in Fungi of Switzerland - Volume 1 - Ascomycetes, is another member of the Diaporthales.
(9) Order Leotiales Class Leotiomycetes: 13 families, 400 genera, 2000 species. (Note that the Geoglossaceae have now been removed from this Class). A large assemblage termed the 'inoperculate discomycetes.' The apothecial ascomata are superficially similar to those of the Pezizales, but the asci are inoperculate, and usually have amyloid apical rings. This suggests to me that the two major kinds of apothecial ascomata are examples of parallel or convergent evolution. Several of the families in this order are common and well-known, so four of them are dealt with below.
(a) Family Sclerotiniaceae.
Class Leotiomycetes
As the name implies, these fungi often form sclerotia, which may be solid masses of fungal tissue, or may be of mixed origin -- fungal hyphae riddling a mummified host such as a peach, plum, cherry or blueberry, or a catkin (right and below, in Ciboria amentacea). Having overwintered in this guise, they germinate in spring and use the stored energy to produce stalked apothecial ascomata (below). Ascospores (primary inoculum) are shot when the host is in flower, and gain entrance through the stigma.

The illustration above is from Fungi of Switzerland, which I recommend to you all.


The anamorphs are generally responsible for secondary dispersal, and some cause serious plant diseases. For example, the soft brown rot of peaches (above, left) is produced by a Monilia anamorph of Monilinia. The greyish powder on the surface of the peach (above, left) and the cherry (below) is made up of masses of branched blastic-acropetal chains of conidia (above, right).
The longer I leave the ripe cherries on my cherry tree, the more of them will succumb to the Monilinia soft brown rot, as the conidia being produced on one cherry (far right) infect others
(see Chapter 12).

Monilinia vaccinii-corymbosi causes mummyberry, a serious disease of cultivated blueberry. Shoots infected by this fungus become ultraviolet-reflective, and release a fragrance and sugars - three features that attract pollinators.
These insects then transfer the Monilia conidia to the flowers, initiating new infections.

The mummified berries that result from these infections are pseudosclerotia (a mixture of plant and fungal tissue).

The mummified berries overwinter, then germinate to produce Monilinia apothecia that release the primary inoculum (ascospores) to start the cycle again.

Another Monilinia produces spur blight of wild cherry (below), killing back young shoots and forming new conidia on the leaves.

Grey mould of strawberry (below) is caused by Botrytis cinerea, the anamorph of Botryotinia fuckeliana.

Botrytis cinerea (holomorph = Botryotinia) is a very common grey mould that can also be seen fruiting on dead flower heads and overripe blackberries (below) during damp weather in late summer and fall.

And a bright red flower head of geranium (Pelargonium) (below, left) can turn into a rather sorry looking grey mess (below, right) in about a week. This is Botrytis cinerea at work.


Here is a young, branched conidiophore of Botrytis, highly magnified, showing the development of blastic-synchronous conidia on small terminal vesicles.

Many members of the Sclerotiniaceae have distinctive anamorphs (see above and
Chapter 4a), while the teleomorphs are relatively uniform. So some of the holomorph genera erected for the teleomorphs have atypically been distinguished by characters of their anamorphs -- and even named after them. So we have Sclerotinia with Sclerotium (sclerotial) anamorphs, Monilinia with Monilia anamorphs (blastic-acropetal), Botryotinia with Botrytis anamorphs (blastic-synchronous), and Streptotinia with Streptobotrys anamorphs (blastic-sympodial).
Sclerotium, Monilia and Botrytis
cause several serious plant diseases (see above and
Chapter 12), but when Botrytis grows on
overripe grapes in certain areas of France, Germany, Hungary, and South Africa it is
called the 'noble rot' in several languages ('pourriture noble', 'edelfaule') because the
small quantities of sweet dessert wine that can be made from such shriveled grapes have
intense and exquisite flavour, and can be sold for very high prices. Find out what a
bottle of Chateau d'Yquem sauternes from France (or a 'Trockenbeerenauslese' from
Germany, or a good Tokay from Hungary)
costs at your local wine store: be prepared for a shock. The full story and some pictures
can be found in Chapter 19.
(b) Family Phacidiaceae
Class Leotiomycetes. Some Phacidium spp.
cause snow blight diseases of conifers, as these two photos of extensive damage to Abies
foliage demonstrate.


If we look more closely, we will see that this family is not typical of discomycetous
fungi in general, since the ascomata develop inside host tissue, and are at first
covered by a thick roof of dark fungal tissue, as in the diagram (below).
But at maturity
the roof splits open and exposes the hymenium. The apical ring in the asci is
amyloid (I+). Compare this family with the order Rhytismatales, a little lower on
the page...How do these orders differ?

Phacidium has coelomycetous anamorphs: those of pathogenic species such as P. coniferarum belong to Apostrasseria (below)...

...while those of saprobic
species like P. betulinum belong to Ceuthospora (below).
The two sets of photomicrographs show vertical sections through
the pycnidial conidiomata, and details of the conidiogenous cells and conidia under phase
contrast illumination.
Can you tell from these pictures how the two anamorph genera, Apostrasseria (above) and Ceuthospora (below), can be differentiated?


(c) Family Geoglossaceae Now (surprise) placed in a separate Class Lichinomycetes.
The family name means 'earth-tongues' - they produce unusual stalked, somewhat flattened and tongue-like, or sometimes pileate, ascomata which emerge from the ground. The hymenium doesn't line a cup or saucer, but covers the convex upper surface of the ascoma, which is fleshy and yellow in Spathularia (above), tough and black in Microglossum, Trichoglossum and Geoglossum (below, left).



If you squash a tiny piece of the hymenium of a mature Geoglossum ascoma, you will see the asci, each of which contains a bundle of 8 long, parallel, phragmoseptate brown ascospores (above, centre). A single 7-septate (phragmosporous) ascospore is shown in the upper right-hand picture (The number of septa in the ascospore is diagnostic).

Cudonia (below) is a pileate (bearing a well-differentiated beret-like cap) genus of the Geoglossaceae. C. grisea (above) is common in spring on decaying wood on the Pacific Northwest.
The illustration of Cudonia circinans (below) is from Fungi of Switzerland Volume 1, a work all those who are interested in the ascomycetes should consult regularly. Note its admirable inclusion of both macroscopic and microscopic characters.
Mitrula produces what looks like a small version of Spathularia. One of the common species, Mitrula paludosa (below, approx 3x), grows on dead leaves in bogs or other wet places. This one was in a shallow stream beside the trail to Botanical Beach, Vancouver Island, B.C.

(d) Family Leotiaceae Class Leotiomycetes contains some more normal-looking 'discomycetes' such as Bisporella, which produces those small yellow discoid apothecia so common on fallen, decorticated tree-trunks...

...while Chlorociboria, also fairly common, stains wood a deep green and forms small, vivid green apothecia on rotten logs.

Another rather spectacular member of this order is Bulgaria inquinans, found on wood of deciduous trees. The apothecial ascomata have a rubbery texture, and the hymenium is jet black.
(This picture is from "The Wild
Mushroom" by George McCarthy, which I recommend to those with an eye for fine
photographs of macrofungi).

Less typical
are the spectacular ascomata of Leotia: these are much larger, stalked,
jelly-like, and have beret-like convex fertile heads (Leotia lubrica below, left and
the beautiful velvety green and translucent yellow Leotia viscosa below, right).


(e) Family Dermateaceae includes Diplocarpon rosae
(which, with its Marssonina anamorph, causes black spot of roses - see illustration in Chapter 12), and a
common but interesting fungus, Trochila ilicina, that fruits on dead leaves of
holly (Ilex) in our garden. Here are several illustrations that will put you
in the picture. Below, left, a scan of a dead holly leaf showing numerous fruit bodies
all over the upper surface. Below, right, the closed fruit bodies under the
dissecting microscope.


These ascomata have a hinged lid, which opens when the leaf is kept in a damp chamber
(below, left). The exposed hymenium contains thousands of asci like that shown
below, right.


(f) Family Vibrisseaceae is
a small family with filiform (thread-like), multiseptate, fragmenting ascospores. It
has interesting stream-dwelling anamorphs (Anavirga).
This
illustration of Vibrissea truncorum (below) is from the
highly recommended Fungi of Switzerland.
(10) Order
Cyttariales
Class
Leotiomycetes:
1 genus, 10 species.
The
globose compound ascomata appear on the branches of the Southern Beech
(Nothofagus) in Chile, Argentina and New Zealand. They seem to
be made up of many apothecial ascomata packed together, as the
photographs (left and below) show. In South America they are
eaten and used to make an alcoholic beverage
(see Chapter 18)
(photos courtesy M.
Wingfield,
D. Minter)



(11) Order
Rhytismatales Class
Leotiomycetes: 70 genera, 400 species.
The
ascomata develop immersed in host tissue or a fungal stroma, which ultimately
ruptures to expose the hymenium. The asci often have apical rings, but these are small and chitinoid (do not stain blue in iodine). The ascospores are usually long and
thin

The genus Lophodermum (above) is
sometimes endophytic and asymptomatic in pine needles for much of its life, but eventually
fruits after the needles die (see Chapter 11).
The picture (below) is of a
transverse section of a pine needle that has been colonized by Lophodermium -- the
section passes through two ascomata. Note the built-in thin-walled area in the roof
of each ascoma, at which it will split open in order to shoot its ascospores.

Rhytisma acerinum (below) causes 'tar spot' of red maple leaves in Eastern N. America...

...while Rhytisma punctatum (below) produces a similar syndrome on big-leaf maple in Western North America, but the small, individual stromata do not fuse. In this photo, the fungus appears to be prolonging the life of the leaf tissue surrounding its colony.

Coccomyces colonizes leaves of Oregon grape (Mahonia) developing polygonal ascomata in the leaves, the black roof made up a ring of triangular black valves that eventually open to reveal the hymenium. The fourth and fifth (phase contrast) pictures are of an ascus and some ascospores. Note that the ascospores have a sort of gelatinous sheath.





(12) Order Clavicipitales: 27 genera, 270 species. Now placed in Order Hypocreales, Class Sordariomycetes
This order comprises a group of highly evolved and sophisticated, obligately parasitic fungi with: (a) frequently stalked, all-fungal stromata (below, A,B,D,E), (b) long asci without apical rings, but with thickened tips (below, right, F), and (c) long, thread-like ascospores that in some taxa fragment at or following release (below, right, F). They have some interesting anamorphs, including Tolypocladium, Polycephalomyces, and Neotyphodium (which used to be called Acremonium, until it was realized that the holomorphs were in different Orders).
Three bizarre and spectacular genera, Claviceps, Cordyceps and Epichloë,
will give us a snapshot of this fascinating order.

(1) Claiceps purpurea (A,B,C above) discharges its
ascospores when its main host, rye, is in flower, and infection takes place through the
stigma. As the infection progresses, the fungus takes over the food being channeled into
seed-production by the host. The ovarian tissues are replaced by a mycelial mat that
produces masses of conidia of the Sphacelia anamorph in a sweet-smelling nectar.
Insects are attracted to the nectar, and spread the conidia to other host plants. The
mycelial mat hardens and becomes a purplish sclerotium -- the ergot --
which replaces the grain (drawings A and B above, and scan below).

I found the ergots shown above at Whiffin Spit, Sooke, Vancouver Island, on Elymus
mollis, a large grass that grows along the shore in the Pacific NorthWest. The
largest ergot in the scan above is 4 cm long and almost 5mm wide. These sclerotia
fall to the ground in Autumn, overwinter, and germinate the following Spring, each
producing several stalked stromata (drawings B and C above, and photos below). Each
stroma has a spherical head within which many perithecia develop around the periphery just
below the surface.

Because this fungus has a small target, the stigma of the grass flower, which is
available only during a narrow time-window, and because spores reach it only by chance,
the fungus must disperse a large number of ascospores in a short time. A rough calculation
suggests that a single ergot can give rise to 5 stromata, and each of those may contain
100 perithecial cavities, each cavity with 50 asci, and each ascus producing eight
ascospores: a total of 5 X 100 X 50 X 8 = 200,000 propagules per ergot.
If the sclerotia are accidentally consumed by cattle, or if rye bread made from ergoty rye is eaten by humans, a large number of alkaloids found in the ergot cause a form of poisoning known as ergotism, or, more picturesquely, St. Anthony's Fire. Human victims frequently hallucinate and feel that they are burning (see chapter 21 for a fuller account of this mycotoxicosis). The alkaloids ergotamine and ergotaline cause contractions of the smooth muscles, and the ensuing restriction of the peripheral blood supply can lead to gangrene and even death. St. Anthony's Fire was fairly common in the Middle Ages, and sporadic outbreaks occurred until recently. Ergot, the only fungal structure in the British Pharmacopoeia Codex, has been used in obstetrics both to induce childbirth and to control post-partural bleeding. Another species of Claviceps brought the genus renewed fame, or perhaps I should say notoriety, as the prime source of LSD (lysergic acid diethylamide), one of the most powerful psychedelic drugs (it is a hundred times more potent than psilocybin, the active ingredient of `magic' mushrooms).
(2) Cordyceps
species (drawing D above, and several
illustrations below) are bizarre: they generally parasitize insects, spiders
and mites, or
hypogeous fungi, and their large stromata spring up directly from their victims. These
perithecial stromata, arising from an insect larva or pupa (below), are known as vegetable
caterpillars, in recognition of the fact that they always incorporate elements from more
than one kingdom.



"These strange 'two Kingdom' structures are used in traditional Chinese
medicine (below), as a treatment for "general debility after illness, weakness,
spitting of blood caused by TB ...chronic coughing and asthma ...night sweating
...anaemia
... malignant tumour."

Cordyceps sinensis (above)
traditionally bundled with red thread, can be purchased in many Chinese
pharmacies, but most people do not know where it comes from. You
may be surprised to learn that most of the supply is collected at high
altitudes in Tibet.
Yartsa Gunbu, as Tibetans call it, parasitizes the
larvae of small white butterflies of the genus
Thitarodes (formerly Hepialus). It occurs in alpine
pastures at altitudes of 3000-5000 m, but most
commonly from 3800 m to 4500
m. In Litang County, collectors are allowed to gather these
fungi only in their legal grazing areas. Outsiders have to pay a fee to
the local government for the right to collect. Not surprisingly, there
are reports of conflicts between locals and unlicensed intruders.
The harvest of Cordyceps sinensis, which is
collected in early spring in all grasslands across the Tibetan Plateau,
is substantial. Estimates for the present annual harvest in Litang range
up to 5,000 kg, representing 5 to 10 million specimens. For comparison,
old statistics for Xikang Province report a Cordyceps harvest of
15,000 kg in 1939. Between 1949 and the mid-1980s the annual Cordyceps
harvest ranged between 5,000 and 20,000 kg in Ganzi Prefecture.
Cordyceps sinensis makes up about 95% of the fungal market in
Tibet. Considering that it is worth $30,000/kg retail, this is not
surprising. This one fungus contributes about 40% of the rural income in
Tibet.

and of Cordyceps sinensis and its host, partly excavated in their natural habitat.

During my recent visit to Japan, this specimen of Cordyceps neovolkiana (above) arising from a beetle larva was spotted in a rotten log at Kikuchi Glen near Kumamoto by my guide, Dr. Hitoshi Neda.
For me, this find maintained Japan's reputation as the world centre for Cordyceps. I took two photos through the dissecting microscope with my digital camera and stitched them together after I got home to produce the result seen here.
Before I left Japan I obtained a copy of the classic Japanese book on Cordyceps and related genera, by Shimizu and Kobayasi (ISBN 4-259-53866-7) Its English title is "Illustrated Vegetable Wasps and Plant Worms in Colour" and it contains literally hundreds of superb colour paintings of these fungi. It is a mycologist's and a bibliophile's delight. Some of the paintings could clearly inspire the makers of science fiction movies. Seek it out!
To see some pictures from it, click
here
A few species of Cordyceps don't pick on arthropods, but
cannibalistically attack another fungus - actually, it's even another ascomycete - the
deer truffle (Elaphomyces). (bottom left) the large, stalked stroma of Cordyceps
capitatus can be seen emerging from the host truffle. (bottom middle) a close-up of the
head shows the ostioles of hundreds of perithecial cavities, and a slice of the head
(bottom right) reveals their orientation.



Here is another species, Cordyceps ophioglossoides, that
also attacks Elaphomyces. Every September for many years, during our
mycology field course, we found this species parasitizing Elaphomyces along one
of the hiking trails in Algonquin Park, Ontario. Once one of the students had
spotted the club-shaped stroma of the parasite, excitement ensued as we dug down,
following the yellow rhizomorphs of the fungus, until we finally excavated the host.
This find was often dubbed - and with good reason - "fungus of the day," though
perhaps that title should have been pluralized.

I am a member of a small group of
Canadian west-coast mycologists, supported by a grant from the Mellon
Foundation, who have been compiling an inventory of the macrofungi of
Clayoquot Sound. On our November 2001 collecting trip, we made an
exciting find -- a species of Cordyceps previously unreported
from the west coast, arising from coleopteran pupae buried in the sand
dunes on a rarely visited beach at the northern end of Pacific Rim
National Park. The two photographs below document that find. In
the first, you can see the head of a compound ascoma emerging from the
sand between the two digging hands.

The second picture shows several
excavated stromata and the sand-covered hosts.

I took the next picture in a cloud forest in Ecuador during April
2002. We were excited to find a spectacular Cordyceps that
had killed a huge bird-eating spider (Mygale).

The next picture gives you some idea of the size of the spider...

Cordyceps species, which must infect target organisms that are clearly far
scarcer than rye flowers, go a big step further than Claviceps in the
multiplication of propagules. In some species, each of the 8 long ascospores breaks up into
128
part-spores, often while still in the ascus (below). I estimate that the usually single
large stroma produced by some species bears
more than 3000
perithecial ascomata, each containing at least 200 asci (seen in squash, below, left),
each ascus containing 8 spores, and each of them fragmenting into 128 part-spores (look at
the beaded appearance of the asci, below, centre, and at the single ascospore, below,
right), for a total of 3000 X 200 X 8 X 128 = 614,400,000 propagules -- all
from a single stroma.
Ophiocordyceps lateralis attacks carpenter ants, and affects their behaviour in some fascinating ways. Although the ants nest high in the forest canopy, the infected ants descend to points about 25cm above the forest floor, then clamp their jaws into the underside of a leaf before dying. The fungus proceeds to fruit, the ascoma emerging from the back of the ant's head, and soon raining spores down on places where other ants may be passing by. Although the interior of the ant is largely destroyed, the fungus seems to leave the jaw muscles alone, so that the ant will remain in place. This again marks the Clavicipitales as among the most sophisticated (if one may use such a word about a parasitic fungus) ascomycetes. There is a video on YouTube showing this process. Type in 'Cordyceps fungus' and you will be able to watch a 3-minute movie (done by the BBC). Distinctly creepy.
A recent paper (Hywel-Jones (2002) Mycological Research 106: 2-3) points out that the number of part-spores in Cordyceps varies. Since there are about 300 species described in Cordyceps, there is a need for some subdivision. Neocordyceps is restricted to attacking Hymenoptera (wasps, ants, bees). The ascospores of Neocordyceps always break up into 64 part-spores. In Eucordyceps, some species also produce 64 part-spores, but others, like C. militaris and other species that are parasites of Lepidoptera (butterflies and moths) and in some cases Coleoptera (beetles), always produce 128 part-spores. Ascospores of species attacking cicadas (Homoptera) commonly break up into 32 part-spores, some species attacking spiders (with Akanthomyces anamorphs) produce only 16 part-spores. Only one known species produces fewer than 16 part-spores -- a recently described species from Coleoptera that has spores which divide into 4. At the other extreme, no species has been observed to produce 256 part spores. Perhaps at that point they would be getting too small to carry the necessary nucleus and food reserves.
Hywel-Jones ends his article with the
statement: 'Molecular phylogenetics, classical morphology and field
observation must be used together to provide a holomycological approach to
fungal classification. Without this approach, confusion can...ensue,
especially in...megagenera such as Cordyceps.' Recent
molecular studies (2005) show that the large genus Cordyceps is not
monophyletic, and that species occur throughout the Clavicipitaceae,
which consists of three major clades. The morphological characters most
consistent with phylogeny are: (1) colour and texure of stromata, (2)
presentation of perithecia, and (3) anamorphs.
Here is a series of pictures that zoom in, starting with a tangle of long asci from a
squashed perithecial cavity (below, left) and ending with a single spore (below, right).




Many of the anamorphs of the Clavicipitales are in the Acremonium-like genus Neotyphodium, with simple, tapered phialides, but in 1996 one species of Cordyceps, C. subsessilis, was discovered to be the holomorph of Tolypocladium inflatum. So what, you might say, until you realized that Tolypocladium inflatum is the fungus that produces the medically important, selective immunosuppressant, Cyclosporine, which has made the organ transplant revolution possible.
(3) Epichloë causes 'choke' disease of grasses. On the (bottom left), a grass called Glyceria growing normally - with open, nodding inflorescences. On the (buttom right), the energy for the inflorescences has been stolen by the fungus, and used to produce a perithecial stroma that surrounds the stalk of the grass (the vertical whitish lines).


On closer inspection, these lines are seen to be creamy yellow fungal stromata (bottom left), each incorporating many perithecia. A transverse section (bottom middle) reveals the peripheral perithecial ascomata, and the sheathing grass blades entirely encased in fungal tissue. Individual long, narrow asci can be seen in one of the perithecial ascomata (bottom, right).



In a recently discovered twist to this story, this apparently damaging parasitic fungus has been found to have a mutualistic symbiosis with the grass. The simple, phialidic anamorph of Epichloë (which used to be called Acremonium, but has recently been segregated into a new anamorph genus, Neotyphodium), grows systemically throughout the grass plant without producing any disease symptoms, and actually protects the grass from herbivores by producing a virulent neurotoxin. A more detailed discussion of this relationship is given in Chapter 21.
To enjoy several wonderful paintings of
members this bizarre group, taken from the superb Japanese book mentioned
earlier, please click
here. Don't miss them!
A wide-ranging book about the group, entitled 'Clavicipitalean Fungi',
edited by White et al., has been published (September 2003). The
full reference is given at the end of the chapter.
(13)
Order
Erysiphales
Class Leotiomycetes: 28 genera, 100 species.
All members of this order are
obligate parasites on leaves and fruits of higher plants, causing diseases called
powdery
mildews. These fungi have superficial mycelium which extracts nourishment from
the host plant through specialized hyphae that penetrate the epidermal cells of the host
and develop special absorbing organs called haustoria. You should have no
difficulty spotting a few powdery mildews in summer; their whitish colonies growing on
living leaves are unlike anything else (on squash, below, left). In dry summers, they are
particularly common on grass in shady parts of lawns, on squash plants
(below, left), on perennial Phlox,
on Alnus rugosa, and many other angiosperms
(over 1,000 species).


Basauxic chains of conidia of
the Oidium anamorphs (SEM picture, above right,
and light micrograph below), whose powdery, whitish appearance
gives these diseases their name (above left),
arise from the mycelium in early summer.
(Oidium on grass (above): picture
courtesy of Jose Rodriguez)

Airborne conidia spread the disease from plant to plant, and are later succeeded by
dark-coloured ascomata (below) - of Uncinula in
this case -which mature slowly in fall, and release ascospores
the following spring. The order
Erysiphales parasitizes well over 1,000 higher plant species, and the
powdery mildews of grapes, hops, gooseberries and cereals are economically important
diseases.

The generic concepts in this order are unusually straightforward and easy to apply;
they depend on two major features of the ascoma -- the number of asci within it, and the
kind of appendage growing out from it (see table below). In one way, the Erysiphales are the antithesis
of the Sclerotiniaceae. There, the anamorphs were far more distinctive and diverse than
the teleomorphs; here, the reverse is true. Most anamorphs of the Erysiphales belong to
the hyphomycete genus Oidium, though a few other
anamorph genera have been recognized - see below (from Boesewinkel 1980)

Although the order Erysiphales is very easy to
characterize and recognize, its systematic position is controversial. Some mycologists
insist that its asci are bitunicate, which would place it alongside the Dothideales (see
below), but many mycologists do not accept this, and place the order among the unitunicate
ascomycetes. The asci are sometimes rather thick-walled, but one of the world experts
on
the group, Dr. Zheng Ru-yong, of Beijing, tells me that she has seen distinctive inner and
outer wall layers only in an undescribed taxon from Tibet, and has never seen the
"Jack-in-a-box" mechanism so typical of the bitunicatae. The asci seem to have
neither an operculum, nor an apical ring apparatus. This information, plus their strange
arrangements for dispersal and dehiscence (see chapter 8), their unique anamorphs, and
their obligately parasitic yet strangely superficial lifestyle, make them a rather
peripheral (though important and interesting) group.
Key to Some Common Genera of Erysiphales
| Appendage type | One ascus per ascoma | More than one ascus per ascoma |
|---|---|---|
| Appendages like assimilative hyphae | Sphaerotheca | Erysiphe |
| Appendages dichotomously branched at end | Podosphaera | Microsphaera |
| Appendages curled at end | Uncinula | |
| Appendages needle-shaped, with bulbous base | Phyllactinia |
Use the key given above to determine which genus is represented by the three photomicrographs below.



(large photomicrograph above, courtesy of Jose Rodriguez)


Use the key again to identify the genus shown in the two photos above. Can you be sure of your identification? If not, why not?
It's easy to identify the genus illustrated below, since there's only one in the key with needle-like appendages with a bulbous base. Phyllactinia has some interesting adventures, which I will try to explain with the aid of several pictures.

Here is an alder leaf (above) with several extensive colonies of Phyllactinia. Below, under the dissecting microscope you can see some developing ascomata with unique appendages. The bulbs, which have differentially thickened walls, develop first, then the needle-like extensions grow out. At maturity, as they dry out and collapse, the bulbs distort, causing the appendages to bend downward and lever the ascoma off the leaf surface, breaking its connections with the mycelium (below).




It is then free to fall away, the appendages acting as stabilizing vanes so that the ascoma will fall straight downward, and become attached to a new substrate by the large blob of mucilage on its top. This has been secreted by specialized hyphal cells with fine apical branches. These cells and the mucilage can be seen in the drawings below.

This new position leaves the asci, which are designed to shoot their spores, facing downward (the third drawing above). The final chapter is written when the ascoma splits around the equator at a built-in line of weakness, and hinges open so that the spores can be shot away.
Here is a wonderful photomicrograph of Cystotheca wrightii (below). Cystotheca is a genus not included in the key given above. Note that there is only one ascus per ascoma, with 8 ascospores. How would you change or add to the key to incorporate this genus?
This picture was very kindly provided by Jose Rodriguez.

If you would like to see more of the
genera that are placed in the Erysiphales (and some of them are
pretty weird-looking), I have inserted a separate page of
illustrations.
Click here to see
it.
Series Prototunicatae
In the following four orders, the walls of the asci break down when the ascospores mature, and therefore the spores cannot be forcibly ejected. This has led to the evolution of new ways of dispersing the spores.
(14) Order
Onygenales Class Eurotiomycetes:
40 genera, 120 species.
Here belong some unusual fungi which cause skin diseases in people
(below, left), and can digest hair, horn and feather (below right, a picture of Onygena
fruiting on what was once a robin - photo courtesy of Paul Kroeger) -- all because they
have the unusual ability to metabolize that rather resistant protein, keratin.


Onygena equina (above - from Fungi of Switzerland -
Volume 1 - Ascomycetes ) producing its stalked mazaedia on shed
horns and hooves.
This Order has traditionally been divided into 4 families:
Arthrodermataceae, Gymnoascaceae, Myxotrichaceae and
Onygenaceae. Many members are keratinophilic, producing simple
thallic-arthric conidia, and some genera in each family have ascomata with
reticuloperidia - loosely-woven, mesh-like 'walls', though which
ascospores can easily escape at maturity - look at the pictures below.
Auxarthron, with 12 species, is a member of the Onygenaceae.
The scanning electronmicrograph below (Skinner et al. 2006) shows very
beautifully the groups of ornamented ascospores and some of the hyphae of
the reticuloperidium,

The members of
one family, the Myxotrichaceae (genera Myxotrichum,
Pseudogymnoascus and Gymnostellatospora) are atypical,
partly because they are cellulolytic, and partly because they have more
complex thallic-arthric anamorphs classified in genera like
Oidiodendron. Developmental and molecular information now
suggests that this family is more closely related to the inoperculate
discomycetes (Tsuneda and Currah 2004). The three pictures below are of
Myxotrichum ascomata - the first two are of M. deflexum, and
the third of M. chartarum, with its spectacular coiled appendages
(My thanks to Dave Spero for this image).
Note that in addition to having a reticuloperidium, these fungi develop long,
coiled or barbed appendages adapted to dispersal by hitching rides on passing
arthropods.



Family Arthrodermataceae
contains the genera Arthroderma
(anamorphs in Trichophyton) and Nannizzia (anamorphs in Microsporum),
the infamous dermatophytes which cause superficial mycoses ranging from
the inappropriately named ringworm of the scalp to another misnomer, athlete's foot (you
certainly don't need to be athletic to catch it) - see Chapter 23.
Other members of the
Onygenales can degrade cellulose, and yet others are coprophilous (dung-inhabiting). They
all produce ascomata, but although these are theoretically cleistothecial, their walls,
as mentioned above, may
be very loosely woven, and in some the ascospores can simply fall out through the gaps.
The asci are always more or less spherical, never shoot their spores, and tend to break
down at maturity. Because of my earlier conclusion that asci evolved as spore-shooting
devices, I assume that the ascoma and asci in the Onygenales are
'reduced' forms,
simplified during evolution from an earlier spore-shooting design. The ascomata often bear
highly characteristic coiled or branched appendages that can make identification easy --
if the teleomorph is present. The ascoma illustrated below
is that of Ctenomyces, which has
comb-like appendages that are adapted
for dispersal by attachment to small animals or to the hairs of larger ones.
(picture courtesy of Dave Spero).

If you isolate dermatophytes in pure culture, they may or may not produce teleomorphs. But
they will develop characteristic thallic conidial anamorphs (below). Sometimes these
produce small, thallic-arthric conidia (Chrysosporium or Malbranchea),
sometimes large, spindle-shaped, transversely septate, solitary thallic conidia (Trichophyton
or Microsporum), and sometimes the same culture will produce both
kinds of conidia.
When a fungus has two or more different anamorphs, these are called
synanamorphs.
The three most important anamorph genera of dermatophytes are Epidermophyton, Microsporum
and Trichophyton. Of these, Epidermophyton has no known teleomorph, 9
species of Microsporum have teleomorphs in Nannizzia, and 7 species of Trichophyton
have teleomorphs in Arthroderma.

Can you identify the anamorph shown below by comparing the
photomicrographs with the named illustrations above? The left-hand photo shows the
fungus growing on a horse hair. Note that the photo on the right shows several
stages in the development of the conidia. If necessary, check back to the
developmental section in Chapter 4


(15) Order Eurotiales
Class Eurotiomycetes:
50 genera, 140 species.
This largely cleistothecial order contains the teleomorphs of some
of the most successful of all conidial fungi -- the common green and blue moulds of the
hyphomycete genera Penicillium and Aspergillus (colonies of both are
illustrated in the left-hand picture below: the granular colony is of Aspergillus
flavus. Aspergillus conidiophores with their apical vesicles are
shown under high power in the centre picture, the brush-like conidiophores of Penicillium
on the right).



These ubiquitous and almost omnivorous anamorphs are blastic-phialidic, and produce
masses of dry, wind-dispersed conidia. These moulds aren't just extremely successful, they
are of considerable importance to us because they produce antibiotics and mycotoxins, and
cause a lot of food spoilage. Species of Aspergillus have teleomorphs in Eurotium
(a section through a cleistothecial ascoma is shown below, left, and stained ascospores
below, centre) or Emericella, while many penicillia have teleomorphs in the
rather similar Talaromyces or Eupenicillium. The cleistothecial ascomata
of the teleomorphs have impermeable walls one or more cells thick. The asci are scattered
throughout the cavity of the ascoma (i.e., never in a hymenium, as the left-hand picture
below shows); they are spherical, thin-walled, and break down when the spores mature. The
ascospores often have a pulley-wheel shape (as shown in the centre and right-hand pictures
below). Again, it is thought that these fungi are 'reduced' derivatives of spore-shooting
ancestors.



(16) Order Ophiostomatales Class Sordariomycetes: 15 genera, 130 species. The ascomata of this order have long, tubular necks, with the ostiole at the tip (below, left). The asci are not arranged in a hymenium, and autolyse early. The spores ooze out of the ostiole and form a slimy droplet that is supported by a ring of specialized, hair-like ostiolar hyphae at the top of the neck (below, right). These fungi often fruit in bark beetle tunnels, and the elevated spore drop has evolved to ensure that the beetle carries spores with it when it flies off in search of another tree.

The most important genera in this order are Ophiostoma and Ceratocystis. Ophiostoma novo-ulmi causes Dutch elm disease (below), which was introduced into the U.S. in 1930, to Canada in 1944, has since spread right across the continent, and has much more than decimated the American elm.



As of October 2003, there is a huge mountain pine beetle infestation in the interior of British Columbia - it covers an area of more than 700 x 400 km, and affects 72 million cubic metres of wood. One probably unsuccessful way of controlling it is to cut newly infested trees, since the beetles are killed by the sawmill processes. However, the salvaged wood is stained blue by a fungus that is introduced to the tree by the beetle, and such wood, even though sound, will not be accepted by the Japanese, so loses value. The fungus is often a species of Ophiostoma, and this is what blue stain looks like.

This is clearly a major challenge to the British Columbia lumber industry, but Lynn Pont, a female entrepreneur, hopes she has the answer: instead of calling the wood 'bug-killed', call it 'Denim pine' and make a variety of trendy products under this label. She flew off to China in September 2003 with a suitcase full of samples, in a game attempt to open the markets there. Since the truth is that the blue-stained wood has lost little or none of its strength, the problem being largely cosmetic, we wish her luck. Watch out for 'Denim wood' in your neck of the woods...

Ceratocystis fagacearum and its Chalara quercina phialidic anamorph (below) are the cause of another widespread and serious tree disease, oak wilt. The teleomorphs of Ophiostoma and Ceratocystis are very similar, but the genera are easily distinguished by their anamorphs: the Chalara anamorph of Ceratocystis has solitary phialides with long, tubular collarettes (below), and forms long, cylindrical conidia (one is emerging from the left-hand phialide); Ophiostoma has several different anamorphs, none of them anything like Chalara.

(17) OrderMeliolales Class Sordariomycetes: 24 genera, 1600 species. This obligately biotrophic, largely tropical order has black, superficial hyphae with lateral appressoria, and black, superficial, cleistothecial ascomata containing evanescent, 2-spored asci. Ascospores usually 4-septate. I found this colony growing on a leaf of salal (Gaultheria shallon) on Vancouver Island.

(18) Order Laboulbeniales Class Laboulbeniomycetes: 75 genera, 1700 species. This group has recently been intensively studied in New Zealand, increasing its representation from 26 taxa to 190 taxa, including about 100 undescribed taxa, which goes to show how much potential there is for increasing our knowledge of many fungal groups. This group is so distinct from the other ascomycetes that some people put it in a separate Class, Laboulbeniomycetes. While that might be justifiable, it would also complicate our classification and make life a little more difficult for you. So, having noted the possibility of such elevated status, I will press on. All 1700 species are invariably found attached to the exoskeleton of insects, or occasionally, millipedes and mites. The left-hand picture below shows a gyrinid beetle with small spiny outgrowth protruding from its upper left quarter. These are shown more highly magnified in the centre, and revealed as ascomata of the Laboulbeniales. The development of Stigmatomyces baerii, which is found on houseflies, is followed in the diagrams below, right. An ascospore (A) becomes attached to the animal, germinates, and sends a foot into the exoskeleton to absorb nutrients. Although haustoria may penetrate as far as the epidermal cells, there is never any real invasion of host tissues. The ascospore develops a median septum, and the upper cell becomes differentiated into a male organ, with several phialide-like cells (B) that produce spermatia. The lower cell then develops an ascogonium with a trichogyne, which is fertilized by the spermatia (C). Several asci then develop from the ascogonium, and eventually deliquesce. The mature ascoma is spine-like, projecting from the exterior of the host, and can be seen with a hand-lens (D). Other genera exhibit the same basic features (Hesperomyces - E and Corethromyces - F).



Newly described Laboulbenialean taxa in Diphymyces (A,D,E,F), Cucujomyces (B) and Rhacomyces (C), found on beetles in subantarctic islands of New Zealand

The Laboulbeniales apparently don't produce anamorphs, so are presumably spread from animal to animal by adhesive ascospores during mating of the hosts, or when insects form dense swarms. This goes some way toward explaining the almost incredible site-specificity of many Laboulbeniales. Various species are restricted to one part of the insect, for example, one side of a particular left limb; or even to one sex of their host, though most species are not quite so limited. The picture below, from a very nice paper by Rossi and Proaño Castro (2009) in Mycologia, shows where the thalli of the fungus (Rhachomyces dimorphus) are attached to the host beetle, and explains how they may be transferred during copulation...so Labouls may be (albeit harmless) STDs!

Series Bitunicatae

These all produce bitunicate asci.
(Again, if you don't remember what these are, look back at the beginning of Chapter 4a)

(19) Order Dothideales Class Dothideomycetes: 50 families, 650 genera, 6300 species. This is an extremely large and diverse order, which will obviously need to be subdivided when its taxonomy is better understood: I will mention only a few common examples, from 7 families.
(a) Family
Venturiaceae.
Venturia inaequalis causes apple scab, an economically important disease. You'll
find the Spilocaea pomi anamorph causing large brownish spots on the
leaves (below, right), and disfiguring blackish scabs on the fruit (below,
left).


It produces its blastic-annellidic conidiogenous cells (below, left --
you can see the rings clearly) and obclavate conidia on those spots and scabs. But you won't find the teleomorph during the growing season.
Its pseudothecial ascomata (seen in section, below, right) develop slowly in the dead apple leaves over the winter, and the ascospores
are shot in spring when the susceptible young leaves appear.


Apiosporina morbosa (below, left) causes the extremely common and disfiguring black
knot of some rosaceous trees, especially wild cherry and damson plum, its pseudothecial
ascomata (below, left) developing on conspicuous black fungal stromata (below, right).


(b) Family Leptosphaeriaceae The
illustration of Leptosphaeria acuta (below) is from the superb Fungi
of Switzerland - Volume 1. This fungus is common on dead stems
of nettle (Urtica dioica) in Spring. Note that the
ascospores are phragmosporous. The anamorph is a Phoma (Coelomycetes),
which looks like the teleomorph, but produces unicellular conidia.
(c) Family Pleosporaceae
Now placed in
Order Pleosporales,
Class Dothideomycetes.
Lewia has anamorphs in Alternaria
(whose beaked, catenate dictyoconidia
are shown below).
Alternaria conidia
are among the most common spores in the atmosphere (see Chapter 8)


Species of Pleospora (above) are common on dead herbaceous stems, and have anamorphs in the dictyosporous hyphomycete genus Stemphylium (bottom left), and the pycnidial coelomycete genus Phoma (bottom right), among others.


Ascospores and conidia in Pleosporaceae are, as you can see above, commonly both dictyoseptate. Phragmoseptate or dictyoseptate ascospores are common throughout the Dothideales; in fact, if a fungus has ascospores of this kind, the odds are about 9 to1 that it is a member of the Dothideales.
(d) Family Botryosphaeriaceae.
Now placed in
Order Botryosphaeriales,
Class Dothideomycetes
Guignardia
aesculi and its Phyllosticta coelomycetous anamorph cause a leaf scorch of Aesculus
(horse chestnut, buckeye) ubiquitous in eastern North America that defoliates many ornamental chestnut
trees a month or so before they would normally lose their leaves.

It doesn't kill the trees, but it is
unsightly, and significantly shortens the
trees' growing season. This disease seems tobe absent from the west coast, since the Aesculus in my
neighbourhood is not afflicted.
(e) Family Capnodiaceae.
Now placed in
Order
Capnodiales,
Class Dothideomycetes
Commonly known
as 'sooty moulds,' these fungi grow on the sugary excreta of various insects
such as mealy bugs and scale insects. I have found their thick black mycelia
producing spectacular black coatings on the trunks and leaves of southern beech (Nothofagus) in the forests of
South Island, New Zealand. It's hard to believe that the tree trunks in the left-hand picture would normally appear whitish. The
black, feathery branches of some of the numerous and diverse anamorphs can be seen in the picture on the right.
Molecular evidence suggests that the Capnodiaceae do not belong
in the Dothideales.


(f) Family Dothioraceae Dothiora
pyrenophora (below), which fruits on dead branches of Sorbus
(Mountain ash), is shown here in an illustration from the highly
recommended Fungi of Switzerland - Volume 1. The ascospores
are dictyosporous, and anamorphs of this family, where known, are
coelomycetous.
(g) Family Hysteriaceae
Now placed in
Order Hysteriales,
Class Dothideomycetes.
Ascomata
opening by a longitudinal split, and sometimes called hysterothecia.
The illustration below, of Hysterium pulicare, is again drawn from the
renowned and unique Fungi of Switzerland, by Breitenbach and
Kraenzlin, in which macroscopic
and microscopic features are always elegantly illustrated side by side.
Mytilidion mytilinellum (below) with
superficial ascomata, also opening by a longitudinal slit, is also from the superb Fungi of Switzerland.
Now I will provide a dichotomous key to 17 of the
traditional orders just discussed. But you will see at
the very beginning of the key that this chapter has by no means dealt with all fungi that
produce asci. Many thousands of fungi are always found in intimate relationships with
algae, and are called lichens (Chapter 7). Many more never produce
ascomata, often have unicellular thalli, and are chemically rather different from other
ascus-producing fungi. These are known as yeasts (see Chapter
6). I have
treated yeasts and lichens separately because each group is phylogenetically diverse, and
includes non-ascomycetous fungi (notably basidiomycetes).
KEY TO 17 ORDERS OF ASCOMYCETES
| 1 No ascoma produced, asci solitary, in chains, or in layer on host | 2 |
| 1 Ascoma produced (open or closed, epigeous or hypogeous) | 3 |
| 2 Hyphae often absent; ascus-like meiosporangia free or produced on individual hyphae |
(yeasts: chapter 6) |
| 2 Hyphae always present; asci borne in a layer on the surface of the host plant |
Taphrinales |
| 3 Thallus containing algal cells or filaments | (lichens: chapter 7) |
| 3 thallus without algae | 4 |
| 4 Ascus wall thick, with two functionally different layers (Bitunicatae) |
Dothideales |
| 4 Ascus wall thin, functionally single-layered, lysing at or before maturity in some orders |
5 |
| 5 Ascus wall lysing before spore maturity; ascospores not forcibly discharged |
(Prototunicatae) 6 |
| 5 Ascus wall persistent; ascospores forcibly discharged except in hypogeous forms |
(Unitunicatae) 9 |
| 6 Assimilative hyphae absent; ascomata on exterior of insects, appearing as spine-like outgrowths |
Laboulbeniales |
| 6 Assimilative hyphae well-developed, immersed or superficial | 7 |
| 7 Ascomata usually with ostiole; asci lysing early | Ophiostomatales |
| 7 Ascomata closed (cleistothecial), occasionally ostiolate; asci spherical, randomly arranged within the ascoma |
8 |
| 8 Ascomatal peridium complete; ascus wall lysing just before maturity; anamorphs usually blastic-phialidic |
Eurotiales |
| 8 Peridium often loosely woven, with characteristic appendages; anamorphs thallic |
Onygenales |
| 9 Asci opening by circular lid (operculate), or with thin apex; ascomata apothecial or hypogeous |
10 |
| 9 Asci opening by apical pore or canal, with apical sphincter or thick apex (inoperculate); ascomata perithecial or apothecial |
11 |
| 9 Asci without lid or sphincter; ascomata closed; obligate plant parasites with superficial assimilative hyphae |
Erysiphales |
| 10 Ascomata apothecial or hypogeous; asci in hymenium | Pezizales |
| 10 Ascomata closed, hypogeous; asci random | Elaphomycetales |
| 11 Mature ascomata have an exposed hymenium | 12 |
| 11 Mature ascomata perithecial (closed but with ostiole) | 13 |
| 12 Asci with apical sphincter blueing in iodine (amyloid) | Leotiales |
| 12 Asci with non-amyloid sphincter | Rhytismatales |
| 13 Asci with apical sphincter amyloid (blueing in iodine) | 14 |
| 13 Asci with non-amyloid ring, or ring absent | 15 |
| 14 Ascomata compound, perithecia radially arranged within a black stroma; ascospores sausage-shaped (allantoid) |
Diatrypales |
| 14 Ascomata single, or compound in a stroma; ascospores not sausage-shaped |
Sphaeriales |
| 15 Ascomata single | Sordariales |
| 15 Ascomata grouped in a stroma or on a subicular layer | 16 |
| 16 Stroma often stalked; asci long, narrow, lacking sphincter, but apex thick, with pore; ascospores long and thread-like, often fragmenting at maturity; all obligately parasitic (on plants, arthropods or fungi) |
Clavicipitales (now included in Hypocreales) |
| 16 Stroma never stalked; asci and ascospores not as above | 17 |
| 17 Ascomata compound, perithecia immersed, with long neck or beak; asci with apical ring but lysing |
Diaporthales |
| 17 Perithecia not beaked, often brightly coloured, embedded in a stroma, or superficial on a subiculum; asci not lysing |
Hypocreales |
Go to Chapter 5a Go to Table of Contents
© Mycologue publications 2020
Further Reading on
Ascomycetes and
their Anamorphs
(Hyphomycetes and Coelomycetes)
Hypocrea / Trichoderma species with conidiophore elongations and green conidia.
Mycologia 95: 1100-1140. Cole, G.T. and B. Kendrick (Eds.) (1981) Biology of Conidial Fungi. (2 Vols.) Academic Press, New York. Cole, G.T. and R.A. Samson (1979) Patterns of Development in Conidial Fungi. Pitman, London. Dennis, R.W.G. (1968) British Ascomycetes. 2nd Edn. Cramer, Lehre. Domsch, K.H., W. Gams and T-H. Anderson (1980) Compendium of Soil Fungi. Vols. 1 & 2. Academic Press, London. Ellis, M.B. (1971) Dematiaceous Hyphomycetes. Commonwealth Mycological Institute, Kew. Ellis, M.B. (1976) More Dematiaceous Hyphomycetes. Commonwealth Mycological Institute, Kew. Ellis, M.B. and J.P. Ellis (1985) Microfungi on Land Plants. An Identification Handbook. Croom Helm, London. Ellis, M.B. and J.P. Ellis (1988) Microfungi on Miscellaneous Substrates. An Identification Handbook. Croom Helm, London. Guarro, J., R.C. Summerbell and R.A. Samson (Eds.) (2002) Onygenales: the Dermatophytes, Dimorphics and Keratin Degraders in their Evolutionary Context.
Studies in Mycology #47. 220pp. Centraalbureau voor Schimmelcultures, Utrecht. Hawksworth, D.L., P.M. Kirk, B.C. Sutton and D.M. Pegler (1995) Dictionary of the Fungi. 8th Edn. CAB International, Wallingford. Hughes, S.J. (1976) Sooty moulds. Mycologia 68: 693-820. Ken, J., R. Summerbell, L. Sigler, S. Krajden and G. Land (1997) Laboratory Handbook of Dermatophytes. Star Publ. Kendrick, B. (Ed.) (1979) The Whole Fungus. (Vols. 1 & 2). National Museums of Canada, Ottawa. (Now available only from Mycologue Publications: see
our store! ) Luttrell, E.S. (1967 reprint) Taxonomy of the Pyrenomycetes. Bibliotheca Mycologica Vol. 6. Cramer, Lehre. Nag Raj, T.R. (1993) Coelomycetous Anamorphs with Appendage-Bearing Conidia. (Available only from Mycologue Publications, 8727 Lochside Dr., Sidney, B.C., V8L 1M8 Canada. our store! ) Nag Raj, T.R., G. Morgan-Jones et al. (1972-1982) Icones generum coelomycetum. Fascicles I-XIII. Department of Biology, University of Waterloo. Rossi, W. and A.C. Proaño Castro (2009) New species of Rhachomyces from Ecuador, one of which is dimorphic. Mycologia 101: 674-680. Rossman, A.Y, G.J. Samuels, C.T. Rogerson and R. Lowen. (1999) Genera of Bionectriaceae, Hypocreaceae and Nectriaceae (Hypocreales, Ascomycetes). Centraalbureau voor Schimmelcultures, Baarn. Seaver, F.J. (1978 reprint) North American Cup-Fungi - Operculates. Lubrecht and Cramer, Monticello, N.Y. Seaver, F.J. (1978 reprint) North American Cup-Fungi - Inoperculates. Lubrecht and Cramer, Monticello, N.Y. Sivanesan, A. (1984) The Bitunicate Ascomycetes and their Anamorphs. Cramer, Vaduz. Skinner, S.J., A. Tsuneda and R.S. Currah (2006) [scanning electronmicrograph of Auxarthron conjugatum on the cover of Mycologia 98:3] Sutton, B.C. (1980) The Coelomycetes. Commonwealth Mycological Institute, Kew. Trappe, M.J., J.M. Trappe and G.M. Bonito (2010) Kalapuya brunnea gen. & sp. nov. and its relationship to the other sequestrate genera in Morchellaceae. Mycologia 102: 1058-1065. Tsuneda, A. and R.S. Currah (2004) Ascomatal morphogenesis in Myxotrichum arcticum supports the derivation of the Myxotrichaceae from a discomycetous ancestor.
Mycologia 96: 627-635. Urban, A., I. Neuner-Plattner, I. Krisai-Greilhuber and K. Haselwandt (2004) Molecular studies on terricolous microfungi reveal novel anamorphs of two Tuber species. Mycol. Res. 108: 749-758. White, J.F., C.W. Bacon, N.L. Hywel-Jones and J.W. Spatafora (2003) Clavicipitalean Fungi. Marcel Dekker, New York and Basel. 640 pp. Winkler, D. (2005) Yartsa Gunbu - Cordyceps sinensis. Economy, Ethno-mycology & Ecology of a Fungus Endemic to the Tibetan Plateau. A.Boesi & F. Cardi (eds.). Wildlife and plants in traditional and modern Tibet: Conceptions, Exploitation and Conservation. Memorie della Societ Italiana di Scienze Naturali e del Museo Civico di Storia Naturale di Milano, Vol. 33.1: 69-85 Ying, J., X. Mao, Q. Ma, Y. Zong and H. Wen (1987) Icons of Medicinal Fungi from China. Science Press, Beijing. Zheng, Ru-yong (1985) Genera of the Erysiphaceae. Mycotaxon 22: 209-263.
